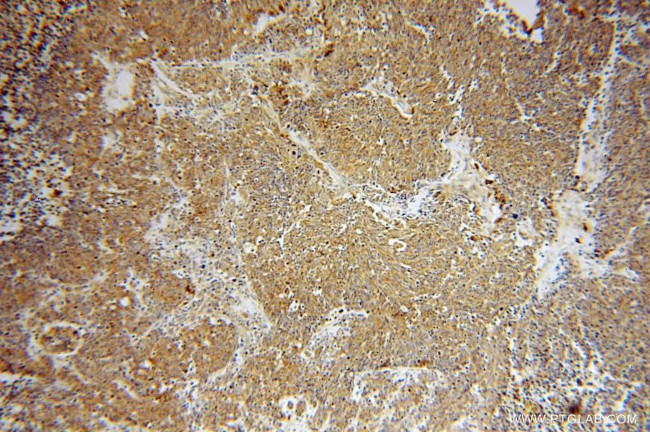
ATP6V1D Antibody in Immunohistochemistry (Paraffin) (IHC (P))

Search
Proteintech
ATP6V1D Polyclonal Antibody
{{$productOrderCtrl.translations['antibody.pdp.commerceCard.promotion.promotions']}}
{{$productOrderCtrl.translations['antibody.pdp.commerceCard.promotion.viewpromo']}}
{{$productOrderCtrl.translations['antibody.pdp.commerceCard.promotion.promocode']}}: {{promo.promoCode}} {{promo.promoTitle}} {{promo.promoDescription}}. {{$productOrderCtrl.translations['antibody.pdp.commerceCard.promotion.learnmore']}}
产品信息
14920-1-AP
种属反应
已发表种属
宿主/亚型
分类
类型
抗原
偶联物
形式
浓度
规格
纯化类型
保存液
内含物
保存条件
运输条件
产品详细信息
Immunogen sequence: MSGKDRIEI FPSRMAQTIM KARLKGAQTG RNLLKKKSDA LTLRFRQILK KIIETKMLMG EVMREAAFSL AEAKFTAGDF STTVIQNVNK AQVKIRAKKD NVAGVTLPVF EHYHEGTDSY ELTGLARGGE QLAKLKRNYA KAVELLVELA SLQTSFVTLD EAIKITNRRV NAIEHVIIPR IERTLAYIIT ELDEREREEF YRLKKIQEKK KILKEKSEKD LEQRRAAGEV LEPANLLAEE KDEDLLFE (1-247 aa encoded by BC001411)
靶标信息
This gene encodes a component of vacuolar ATPase (V-ATPase), a multisubunit enzyme that mediates acidification of eukaryotic intracellular organelles. V-ATPase dependent organelle acidification is necessary for such intracellular processes as protein sorting, zymogen activation, receptor-mediated endocytosis, and synaptic vesicle proton gradient generation. V-ATPase is composed of a cytosolic V1 domain and a transmembrane V0 domain. The V1 domain consists of three A and three B subunits, two G subunits plus the C, D, E, F, and H subunits. The V1 domain contains the ATP catalytic site. The V0 domain consists of five different subunits: a, c, c', c", and d. Additional isoforms of many of the V1 and V0 subunit proteins are encoded by multiple genes or alternatively spliced transcript variants. This gene encodes the V1 domain D subunit protein.
仅用于科研。不用于诊断过程。未经明确授权不得转售。
生物信息学
蛋白别名: ATPase, H+ transporting lysosomal (vacuolar proton pump); ATPase, H+ transporting lysosomal, member M; ATPase, H+ transporting, lysosomal (vacuolar proton pump); ATPase, H+ transporting, lysosomal 34kD, V1 subunit D; ATPase, H+ transporting, lysosomal 34kDa, V1 subunit D; ATPase, H+ transporting, V1 subunit D; H(+)-transporting two-sector ATPase, subunit M; lysosomal 34kDa; unnamed protein product; V-ATPase 28 kDa accessory protein; V-ATPase D subunit; V-ATPase subunit D; V-type proton ATPase subunit D; vac; vacuolar ATP synthase subunit D; vacuolar H-ATPase subunit D; vacuolar proton pump D subunit; vacuolar proton pump delta polypeptide; Vacuolar proton pump subunit D; vacuolar proton-ATPase subunit D
基因别名: 1110004P10Rik; ATP6M; ATP6V1D; VATD; VMA8
UniProt ID: (Human) Q9Y5K8, (Mouse) P57746
Entrez Gene ID: (Human) 51382, (Rat) 299159, (Mouse) 73834